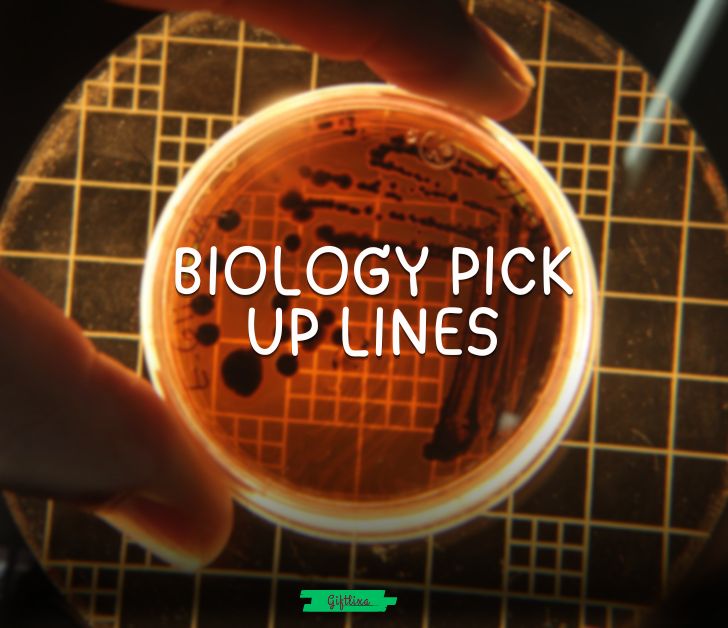
biology pick up lines

69+ Cute Biology Pick Up Lines for Your Crush
Somewhere between heartbeats and chemistry, attraction begins to grow. Love is not just felt, it reacts, multiplies, and evolves. If flirting had a science, biology would be its most romantic chapter. These lines are made for curious hearts, playful minds, and smiles that spread faster than good genes.
Table of Contents
Best Biology Pick Up Lines
- Are you DNA because my world makes sense when you are around
- I must be studying biology because I cannot stop noticing your natural perfection
- You and I have more chemistry than any lab experiment
- My heart races like mitosis every time you smile
- You are the missing piece in my genetic code
- I feel an instant attraction like opposite charges in a cell
- Loving you feels like evolution at its finest
- You activate something deeper than instincts in me
- Our connection feels biologically inevitable
- You make my neurons fire in the best way
- My heart chose you without needing a hypothesis
- You are proof that nature knows what it is doing
- I feel bonded to you on a cellular level
- You turn basic biology into pure magic
- My pulse changes whenever you are near
Dirty Biology Pick Up Lines
- Are you a dominant trait because you take over my thoughts
- My body reacts to you faster than reflex action
- You trigger responses I did not know I had
- Being close to you feels like crossing every boundary membrane
- You stimulate more than just my curiosity
- My senses react to you instantly
- You awaken instincts I usually keep controlled
- Your presence causes a full body reaction
- You make my heart rate spike like intense stimulation
- I feel a deep physical attraction I cannot deny
- You turn natural selection into temptation
- My body clearly recognizes you as a priority
- You activate every signal pathway in me
- I feel chemistry where it really counts
- You make self control feel optional
- You awaken reactions textbooks never mentioned
- Let your heart heal while discovering the cutest Nurse pick up lines
Funny Biology Pick Up Lines
- Are you a cell because you divide my attention
- I failed biology but I still know I like you
- You must be a microscope because you make everything clearer
- My brain forgot everything once you walked in
- Are you evolution because you just upgraded my standards
- I was normal until biology made me think of you
- You make my neurons panic in a good way
- Are you photosynthesis because you brighten my mood
- My heart skipped like a bad lab result
- You are more distracting than a pop quiz
- I came for science and stayed for you
- My focus mutated when I saw you
- You are the reason I forgot my notes
- Biology class never warned me about you
- You caused a reaction I cannot explain
- I blame biology for this crush
Cute Biology Pick Up Lines
- You make my heart feel safe and curious
- Being around you feels naturally right
- You are the soft part of my science brain
- My smile reacts every time you appear
- You feel like comfort written in my genes
- I feel calm and excited at the same time with you
- You are my favorite discovery
- My heart recognizes you instantly
- You bring balance to my whole system
- You feel like home on a cellular level
- I like how you make everything gentle
- You make biology feel sweet
- I feel closer to you without trying
- You are easy to care about
- My heart adapts happily to you
- You make attraction feel innocent
Cheesy Biology Pick Up Lines
- Are you my lab partner because I choose you every time
- You must be science because I cannot resist you
- My heart runs experiments on you daily
- You are the highlight of my syllabus
- I would study you all semester
- You make my brain forget logic
- My heart passed the test when it met you
- You are the answer I was guessing
- I would skip class just to talk to you
- You turn notes into feelings
- I fell for you faster than a reaction time
- You make studying feel romantic
- You are my favorite subject
- I would redo biology just for you
- You make learning feel fun
- My heart says you are correct
Corny Biology Pick Up Lines
- Are you biology because I cannot escape you
- You must be in my genes because you are stuck with me
- My heart says you are scientifically approved
- You make my brain short circuit
- Biology never prepared me for you
- I caught feelings faster than a cold
- You make my heart act weird
- My attraction has no control group
- You are my favorite side effect
- I blame science for this crush
- You are hard to study and easy to like
- My heart chose you without data
- You make sense without explanation
- Biology feels personal now
- You are my favorite result
- My feelings passed inspection
Flirty Biology Pick Up Lines
- You look like someone my heart would choose
- I feel drawn to you naturally
- You make my attention lock in instantly
- Being near you feels exciting
- My body reacts before my brain does
- You have my full focus right now
- I feel chemistry when you smile
- You make attraction feel easy
- I want to learn more about you
- You trigger curiosity in the best way
- I like how you affect me
- You feel dangerously interesting
- My heart keeps leaning toward you
- You look like trouble I want
- I feel a spark I cannot ignore
- You are definitely my type biologically
Short Biology Pick Up Lines
- You feel like chemistry
- My heart chose you
- You spark reactions
- I feel drawn to you
- You activate something in me
- You feel natural
- My pulse reacts to you
- You are my favorite reaction
- I like how you affect me
- You make sense to me
- My heart noticed you
- You feel right
- You caught my attention
- You are intriguing
- I feel the spark
- You feel different
Nerdy Biology Pick Up Lines
- You are statistically significant to my happiness
- My heart ran trials and chose you
- You exceed all my expectations
- You are my favorite variable
- My attraction passed peer review
- You outperform every hypothesis
- You make data feel emotional
- I want to research you deeply
- You are my best result
- My brain finds you fascinating
- You make logic melt
- I would cite you as a source
- You improve my mental health
- You are my preferred outcome
- You stimulate my curiosity
- You make science exciting
Biology Pick Up Lines for Her
- You look like the reason biology exists
- My heart recognized you instantly
- You carry beauty that feels natural
- I feel calmer just seeing you
- You make attraction feel gentle
- You glow without trying
- My focus shifts when you smile
- You feel rare in the best way
- I like how you affect my mood
- You feel like a happy discovery
- My heart reacts softly to you
- You make my world feel balanced
- You have a magnetic calm
- I feel drawn to your energy
- You make science feel poetic
- You brighten my thoughts
- You feel beautifully real
Biology Pick Up Lines for Him
- You have a presence my heart respects
- I feel safe and curious around you
- You make attraction feel effortless
- My attention keeps finding you
- You carry confidence naturally
- You feel grounding and exciting
- I like how you make me feel
- You stand out without trying
- My heart notices your energy
- You feel like strong chemistry
- I enjoy being around you
- You make my smile easy
- You feel dependable and intriguing
- My instincts like you
- You bring calm excitement
- You feel like a great discovery
Related Posts
















